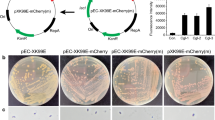

Abstract
Corynebacterium glutamicum is a non-pathogenic, non-sporulating Gram-positive soil bacterium that has been used for the industrial production of various proteins and chemicals. To achieve enhanced and economical production of target molecules, the development of strong auto-inducible promoters is desired, which can be activated without expensive inducers and has significant advantages for industrial-scale use. Here, we developed a stationary-phase gene expression system by engineering a sigma factor B (SigB)-dependent promoter that can be activated during the transition phase between exponential and stationary growth phases in C. glutamicum. First, the inducibilities of three well-known SigB-dependent promoters were examined using super-folder green fluorescent protein as a reporter protein, and we found that promoter of cg3141 (P cg3141 ) exhibited the highest inducibility. Next, a synthetic promoter library was constructed by randomizing the flanking and space regions of P cg3141 , and the stationary-phase promoters exhibiting high strengths were isolated via FACS-based high-throughput screening. The isolated synthetic promoter (P4-N14) showed a 3.5-fold inducibility and up to 20-fold higher strength compared to those of the original cg3141 promoter. Finally, the use of the isolated P4-N14 for fed-batch cultivation was verified with the production of glutathione S-transferase as a model protein in a lab-scale (5-L) bioreactor.
Similar content being viewed by others
Avoid common mistakes on your manuscript.
Introduction
Corynebacterium glutamicum is a non-pathogenic, non-sporulating Gram-positive soil bacterium that is generally recognized as a safe organism (GRAS) (Ikeda and Nakagawa 2003; Kalinowski et al. 2003). Due to its safety and performance, C. glutamicum has been widely used as an industrial producer of various proteins and biochemicals such as amino acids, vitamins, nucleic acids, biofuels, and fine chemicals (Becker and Wittmann 2012; Choi et al. 2015; Park et al. 2014). To increase the expression level of target genes, various genetic engineering of this microorganism has been conducted over the last decade (Liu et al. 2015; Woo and Park 2014; Yim et al. 2013). One of the most effective tools for increasing gene expression involves the engineering of promoters. In general, for the heterologous gene expression in bacterial host, two types of promoters are available: (i) constitutive promoters, which are uncontrolled promoters with continuous transcription of heterologous genes, and (ii) inducible promoters, which are controlled promoters that turn on in response to a specific inducer. Compared to constitutive promoters, inducible promoters show many advantages for the production of recombinant proteins (Mijakovic et al. 2005). Inducible promoters can control the initiation time for the protein production, so they can lower the metabolic load and allow fast growth to high cell density (Lipscomb et al. 2004). In addition, they are useful in the production of toxic chemicals.
Although inducible promoters have many advantages over constitutive promoters, there are also several drawbacks of using inducible promoters. Adding inducers requires monitoring of the cell density and the metabolic state (Nocadello and Swennen 2012). In addition, inducers such as IPTG are often toxic to the cells or too expensive to use in large amounts, so inducible promoters are sometimes not preferred at industrial scales (Donovan et al. 1996; Hansen et al. 1998). To solve these problems, auto-inducible expression systems were developed as alternatives (Nocadello and Swennen 2012). Auto-inducible promoters automatically turn on in response to an effect of their own metabolism, such as nutrient, oxygen, pH, and cell growth phase (Chou et al. 1995; Khosla and Bailey 1989; Miksch et al. 2005; Wanner et al. 1988). Several auto-inducible gene expression systems have been developed in other bacterial species, and their performances in the large-scale production of recombinant proteins have been proven (Cao and Xian 2011; Miksch et al. 2005; Nocadello and Swennen 2012; Panahi et al. 2014). In Escherichia coli, an effective stationary-phase promoter system was developed which produced phloroglucinol with higher titer and lower production cost compared to the inducible T7 promoter system (Cao and Xian 2011). In Bacillus subtilis, a gene expression system based on a sigma factor B (SigB)-dependent native ohrB promoter was developed and produced xylanase via high-cell-density fermentation (Panahi et al. 2014). However, no suitable auto-inducible promoters have yet been developed for C. glutamicum. Therefore, development of auto-inducible promoters is necessary for heterologous gene expression in C. glutamicum (particularly for industry applications).
Here, we sought to develop a SigB-dependent synthetic stationary-phase promoter that turns on at a transition phase between exponential and stationary growth phases and is suitable for heterologous gene expression in C. glutamicum. C. glutamicum has seven sigma factors: the essential sigma factor SigA and the non-essential sigma factors SigB, SigC, SigD, SigE, SigH, and SigM (Kalinowski et al. 2003; Pátek et al. 2011). The primary sigma factor SigA is involved in the transcription of the housekeeping genes. The activity of SigA is high until the exponential growth phase and decreases after the transition phase (Oguiza et al. 1997; Larisch et al. 2007). The SigA-dependent promoters are therefore active in the exponential growth phase. The primary-like sigma factor SigB is used for transcription of some housekeeping genes but mostly has a role in response to stressed conditions from the environmental changes during cell growth, especially during the transition phase (Ehira et al. 2008; Halgasova et al. 2002; Oguiza et al. 1997; Larisch et al. 2007). The expression of SigA decreases at the transition phase, and SigB takes place of SigA by increasing expression of genes with stress-protective functions. So far, several SigB-dependent promoters have been identified in C. glutamicum (Ehira et al. 2008; Larisch et al. 2007; Pátek and Nešvera 2011), but their behaviors on recombinant protein production have not been studied yet. In this study, we first examined SigB-dependent promoters that can be used for heterologous gene expression during the stationary phase in C. glutamicum. Next, using the fluorescence-activated cell sorter (FACS)-based high-throughput screening method, we tried to engineer the endogenous SigB-dependent promoter towards enhanced activity and inducibility in C. glutamicum. Finally, the usability of the engineered promoter for the production of recombinant proteins in large-scale cultivation was validated with a glutathione S-transferase (GST) as a model protein.
Materials and methods
Bacterial strains and culture conditions
All of the bacterial strains and plasmids used in this study are listed in Table 1. E. coli XL1-Blue was used as the host for cloning and plasmid maintenance. Wild-type C. glutamicum ATCC 13032 was used as the main host for gene expression and screening (Kinoshita et al. 1957). E. coli was cultivated at 37 °C in Luria-Bertani medium (BD, Franklin Lakes, NJ, USA) containing 10 g tryptone, 5 g yeast extract, and 10 g NaCl per liter. For plasmid transformation, C. glutamicum was cultivated at 30 °C in recovery glucose (RG) agar plate containing 40 g brain heart infusion (BHI, BD), 10 g glucose, 10 g beef extract, 30 g sorbitol, and 20 g agar per liter. For protein production, C. glutamicum was cultivated in a defined medium containing 20 g glucose, 2 g MgSO4, 3 g K2HPO4, 1 g KH2PO4, 2 g urea, 10 g (NH4)2SO4, 200 μg biotin, 5 mg thiamine, 10 mg calcium pantothenate, 10 mg FeSO4, 1 mg MnSO4, 1 mg ZnSO4, 200 μg CuSO4, and 10 mg CaCl2 per liter. For semi-defined medium, 2 g yeast extract (BD, Franklin Lakes, NJ, USA) and 7 g casamino acids (BD, Franklin Lakes, NJ, USA) per liter were added to defined medium. Kanamycin (Km, 25 μg/mL) was used as a sole antibiotic.
Plasmid manipulation
All of the primer nucleotide sequences are described in the Supplementary material, Table S1. A C1000™ thermal cycler (Bio-Rad, Richmond, CA, USA) and PrimeSTAR HS polymerase (Takara Bio, Inc., Shiga, Japan) were used for polymerase chain reaction (PCR). The promoter region of cg0096 containing the 500 bp upstream region of the cg0096 gene was amplified by PCR with two primers (P cg0096 -F and P cg0096 -sfGFP-R). The promoter region of cg1417 containing the 500 bp upstream region of the cg1417 gene was amplified by PCR with two primers (P cg1417 -F and P cg1417 -sfGFP-R). Promoter regions of cg3141 containing 300 or 500 bp upstream regions from the cg3141 gene were amplified by PCR with the forward primers P cg3141 (300)-F or P cg3141 (500)-F, respectively, and the same reverse primer P cg3141 -sfGFP-R. All promoters were amplified from the chromosome of wild-type C. glutamicum ATCC 13032 as a template DNA. The sfgfp gene was amplified from PRM-GFP (Addgene plasmid 40127, Addgene, Cambridge, MA, USA) as a template DNA by PCR with sfGFP-F and sfGFP-R primers (Pédelacq et al. 2006; Huang et al. 2012). Each PCR-amplified promoter was linked to sfgfp by overlapping PCR with each forward primer (P cg0096 -F, P cg1417 -F, P cg3141 (300)-F, and P cg3141 (500)-F) and sfGFP-R. The PCR products were digested by the restriction enzymes KpnI and NotI, and then they were cloned into the E. coli-C. glutamicum shuttle vector pCES208 (Park et al. 2008) to yield pCES-P cg0096 -sfGFP, pCES-P cg1417 -sfGFP, pCES-P cg3141 (300)-sfGFP, and pCES-P cg3141 (500)-sfGFP. For easy cloning in library construction, a cg3141 promoter (P cg3141 ) containing the NdeI site was created using the primers P cg3141 (500)-F and P cg3141 (NdeI) sfGFP-R from C. glutamicum chromosome. P cg3141 and sfgfp were linked by PCR with P cg3141 (500)-F and sfGFP R primers. After digestion with KpnI and NotI, the PCR product was cloned into pCES208 to yield pCES-P cg3141 (NdeI)-sfGFP. The sigB gene was amplified from C. glutamicum chromosome by PCR using primers SigB-F and SigB-R. After digestion with NcoI, the PCR product was cloned into pCES-P cg3141 (500)-sfGFP to yield pCES-SigB-P cg3141 -sfGFP. For the expression of the GST gene, GST gene was amplified from pJH11 (Park et al. 2013) by PCR with two primers, GST-F and GST-R, and digested with NdeI and NotI. The digested product of GST was cloned into the same restriction enzyme sites of pCES-P4-N14-sfGFP to yield pCES-P4-N14-GST (in which sfGFP was replaced with GST). All plasmid constructions were performed in E. coli XL1-Blue, and the purified plasmid was used for the transformation with C. glutamicum by electroporation using Gene Pulser (Bio-Rad). Manipulation of DNA, such as restriction enzyme digestion, ligation, and agarose gel electrophoresis, was carried out using standard procedures (Sambrook and Russel 2001).
Construction of the sigB-deficient strain
Deletion of the sigB gene in C. glutamicum chromosome was performed by the double cross-over method using the pK19mobsacB vector system (Schafer et al. 1994). First, the 500 bp-length flanking regions of sigB were amplified from the chromosome of C. glutamicum using the primer pair SigB-del-up-F and SigB-del-up-R and the primer pair SigB-del-down-F and SigB-del-down-R, respectively. The flanking regions of sigB were assembled by overlap PCR using the forward primer SigB-del-up-F and the reverse primer SigB-del-down-R. The PCR product was cloned into the HindIII and XbaI restriction enzyme sites of pK19mobsacB to yield pK19mobsacB-ΔsigB. The constructed plasmid was transformed with C. glutamicum by electroporation, and the screening of ΔsigB mutants was performed in 10 % (w/v) sucrose LB plate. The presence of the mutation after curation of the suicide vector was confirmed by screening both kanamycin-sensitive and sucrose-resistant clones. Gene deletion was verified by checking the sizes of the PCR fragments using primers SigB-del-up-F and SigB-del-down R via colony PCR.
Construction of synthetic promoter library
The synthetic promoter library was constructed using the forward primer, Library-F, with degenerated oligonucleotide N, and the reverse primer, Library-R. The upstream region of cg3141 promoter was amplified from C. glutamicum chromosome using primers P cg3141 (300)-F and Linker-R. The upstream region and the synthetic promoter library were attached using the primers P cg3141 (300)-F and Library-R. The PCR product was digested with KpnI and NdeI, then cloned into pCES-P cg3141 (NdeI)-sfGFP, which was digested with the same restriction enzymes. The ligated plasmids were transformed into E. coli XL1-Blue by electroporation. The quality of the randomization was checked by analyzing the sequences of 20 random clones. The synthetic promoter library was purified with Nucleo Bond® Xtra Midi Plus EF (Macherey-Nagel GmbH & Co. KG, Düren, Germany). The purified plasmid DNA was transformed into C. glutamicum by electroporation.
FACS screening
The C. glutamicum library was inoculated into BHI medium and cultivated overnight at 30 °C and 200 rpm. Then, 500 μL of the fully grown cells was transferred into 50 mL of the defined medium in 250 mL shake flasks and cultivated at 200 rpm for 18 h at 30 °C. The cells were harvested by centrifugation at 6000 rpm for 10 min at 4 °C then were washed twice with phosphate-buffered saline (PBS). The cells were resuspended in PBS and sorted on FACS (MoFlo XDP, Beckman Coulter, Inc., Miami, FL, USA) using sfGFP as the reporter protein. The cells were excited by 488-nm laser and detected through a 530/40 band-pass filter. In the first four-round screening, cells showing high fluorescence intensity (the top 1 %) were sorted (positive sorting) (Yim et al. 2013; Park et al. 2012). The sorted cells were poured directly into 50 mL BHI media and cultivated overnight, and then the cells were transferred into 50 mL of defined medium for the next round of screening. In the fifth-round screening, the cells showing low fluorescence intensity (the bottom 1 %) were sorted (negative sorting). After fifth-round sorting, the sorted cells were spread on BHI agar plate and incubated at 30 °C.
Protein preparation and analysis
C. glutamicum was inoculated in 5 mL BHI medium and cultivated at 30 °C and 200 rpm overnight. Then, 500 μL of pre-culture was transferred into 50 mL of defined medium or semi-defined medium in 250 mL shake flasks. The cells were periodically collected during the cell culture. Cell growth was monitored by measuring the optical density at 600 nm using a spectrophotometer (Optizen POP, Mecasys, Daejeon, South Korea). The cells were harvested to an optical density (OD) value of 2 by centrifugation at 6000 rpm for 10 min at 4 °C. The harvested cells were resuspended in 400 μL of PBS. The fluorescence intensities of sfGFP were detected at 488 nm of excitation and 530 nm of emission wavelengths with the TECAN Infinite M200 Pro (Tecan Group Ltd., Männedorf, Switzerland) in black 96-well plate. The fluorescence intensity values are given in arbitrary units.
The production of recombinant proteins in C. glutamicum were analyzed by sodium dodecyl sulfate polyacrylamide gel electrophoresis (SDS-PAGE) and Western blot. For SDS-PAGE analysis, the cytoplasmic proteins were prepared by sonication (10 min at 50 % pulse and 20 % amplitude). The protein samples were analyzed by using 12 % polyacrylamide gels. Equal amounts of protein (10 μg) were loaded onto the gel. After gel electrophoresis, the gels were stained for 1 h with Coomassie brilliant blue staining solution, containing 50 % (v/v) methanol, 10 % (v/v) acetic acid, 1 g/L Coomassie brilliant blue R-250, and then destained using a destaining solution, containing 10 % (v/v) methanol and 10 % (v/v) acetic acid. For Western blot, the proteins in the SDS-PAGE gels were transferred to polyvinylidene fluoride (PVDF, Roche, Basel, Switzerland) membranes using a Bio-Rad transblot apparatus (Bio-Rad, Hercules, CA, USA) for 90 min at 70 mA. The membranes were blocked with 5 % (w/v) skim milk in Tris-buffered saline with Tween-20 (TBS-T, 10 mM Tris, 150 mM NaCl, 0.05 % (v/v) Tween-20) for 1 h at room temperature. For the immunodetection of GST, anti-GST antibody conjugated with horseradish peroxide (HRP) (GE Healthcare, Little Chalfont, UK) was used. The membranes were incubated with the skim milk solution containing the antibody at 1:4000 dilution. The immunoreactive bands were detected using enhanced chemiluminescence (ECL) reagents (Bionote, Hwaseong, Korea).
Fed-batch cultivation
C. glutamicum harboring pCES-P4-N14-GST was inoculated into 5 mL BHI medium and cultivated at 30 °C and 200 rpm overnight. Then, 500 μL of cells was transferred to 50 mL of defined medium in four 250 mL flasks. After 18 h of cultivation, the seed culture was inoculated into 1.8 L of fresh defined media in a 5-L jar bioreactor (BioCNS, Daejeon, South Korea). During the cultivation, the temperature was maintained at 30 °C, and the pH and dissolved oxygen (DO) concentration were controlled at the set points by online monitoring. The pH was controlled to 7.0 by adding 12.5 % (v/v) ammonia solution. The DO concentration was maintained at 30 % (v/v) by automatically increasing the speed up from 200 to 1200 rpm and by supplying pure oxygen through a gas mixer. Glucose solution (90 g in 150 mL) was manually added to prevent glucose starvation and avoid the effect resulting from glucose over-feeding. The glucose concentration was monitored by a glucose analyzer (YSI 2700 SELECT™ Biochemistry Analyzer, YSI Life Science, Yellow Springs, OH, USA).
Results
Investigation of SigB-dependent promoters
To investigate the activities of the SigB-dependent promoters on recombinant protein production, we first tested the promoters of the genes that were studied to show SigB-dependent behaviors. We selected three promoters (P cg0096 , P cg1417 , and P cg3141 ) that are responsible for the expression of cg0096, cg1417 (acetyltransferase), and cg3141 (flavohemoprotein) genes, respectively, whose genes were previously studied to show a significantly elevated expression during the transition phase only in the presence of SigB in the microarray and the RT-PCR analyses (Larisch et al. 2007). Since the exact promoter and regulatory regions of those genes have not been fully defined yet, the 500 bp upstream region from the start codon of each gene, which included the promoter regions (−35 and −10) and regulatory regions, were arbitrarily chosen. Then, the 500 bp upstream regions were amplified from the chromosomal DNA of wild-type C. glutamicum ATCC 13032 and cloned in the upstream of sfGFP in plasmid pCES208. Next, the expression of the sfgfp gene under each promoter in wild-type C. glutamicum was analyzed. Each strain was inoculated in 5 mL BHI medium, and after cultivation at 30 °C and 200 rpm for 24 h, 500 μL of fully grown cells were transferred to 50 mL defined medium in 250 mL shake flasks. As shown in Fig. 1, all strains showed similar growth profiles, and among the three promoters, P cg1417 and P cg3141 could mediate SigB-dependent expression of the sfGFP. We found that P cg3141 exhibited a little faster response to transition of growth phase, and higher inducibility was also observed under the P cg3141 than P cg1417 . When the cells entered the stationary growth phase (about 10 h), the sfGFP began to be expressed immediately, and the content of sfGFP continued to increase gradually during the stationary growth phase (Fig. 1). In contrast, the use of P cg0096 did not show any gene expression in this experiment. From this comparison, we chose P cg3141 for further analysis.
The expression of sfgfp gene under three SigB-dependent promoters (P cg0096 , P cg1417 , and P cg3141 ) in wild-type C. glutamicum. Symbols: Circle (○) pCES208, triangle (△) pCES-P cg0096 -sfGFP, square (□) pCES-P cg1417 -sfGFP, diamond (◇) pCES-P cg3141 (500)-sfGFP. Closed and open symbols indicate the cell density (OD 600 nm) and fluorescent intensities, respectively. The experiments were performed in triplicates and standard deviation is indicated
SigB-dependency of cg3141 promoter
The SigB-dependent property of P cg3141 was further investigated by comparing the cell growth and the production yield of sfGFP in wild-type C. glutamicum and sigB-deficient C. glutamicum strains. In wild-type C. glutamicum, the sfGFP level began to increase when the cells entered the stationary growth phase, and we also found that the expression of sfGFP under P cg3141 was further enhanced by co-expression of the sigB gene (Fig. 2a). In contrast, the promoter activity of P cg3141 was significantly reduced in the sigB-deficient C. glutamicum strain (Fig. 2b). Although cells were in the stationary growth phase, the sfGFP level was not increased in the sigB-deficient strain, but this reduced gene expression could be restored again by the co-expression of sigB gene (Fig. 2b). From these results, we concluded that P cg3141 is strictly controlled by SigB and is a good candidate for the development of stationary-phase gene expression system in C. glutamicum.
The expression of sfgfp gene under the P cg3141 in wild-type C. glutamicum (a) and sigB-deficient (ΔsigB) mutant (b). Symbols: circle (○) pCES208, triangle (△) pCES-P cg3141 (500)-sfGFP, square (□) pCES-SigB-P cg3141 -sfGFP. Closed and open symbols indicate the cell density (OD 600 nm) and fluorescent intensities, respectively. The experiments were performed in triplicates and standard deviation is indicated
Construction of promoter library and isolation of the stationary-phase promoters by FACS
Although the promoter of the cg3141 gene was determined to be dependent on SigB by exhibiting an inducible behavior at the transition phase (Fig. 2), the promoter was not strong enough to be used for high-level production of recombinant proteins at an industrial scale. Therefore, further engineering of this promoter was necessary to increase the promoter strength. By testing the promoter strengths and activities using 300 and 500 bp upstream regions of cg3141 gene, the 300 bp region was selected as the backbone for the library construction because the promoter activities using 300 bp region was similar to the activities using 500 bp region (data not shown). To engineer the P cg3141 , a random library of promoter was constructed using the 300 bp upstream region of the cg3141 gene as a backbone for library construction. The deduced −10 and −35 regions of P cg3141 were fixed to allow SigB binding, and a total of 34 bp (the spacer and flanking regions) were designed to have fully randomized sequences (Fig. 3a) (Larisch et al. 2007). The randomized promoters were cloned in the upstream of the sfgfp gene for the FACS screening. E. coli XL1-Blue was transformed with the synthetic promoter library, yielding 8 x 106 colonies, and then wild-type C. glutamicum was transformed with the plasmids purified from the E. coli library, yielding 6 x 106 colonies. The constructed library cells were cultivated in the defined medium; at 18 h after inoculation, when the cells were in the stationary growth phase, the highly fluorescent cells which indicated the stronger activity of promoters were selectively sorted by high-speed FACS sorter. The fluorescence intensities of the original library population were largely distributed from 100 to over 102, providing a much higher signal than the original P cg3141 (Fig. 3b). In the first round sorting, the population showing the highest fluorescence signal (top 1 % of cells) was selectively sorted and, after overnight cultivation, they were used for the next round sorting. The screening was repeated up to fourth round until the highly fluorescent cells were fully enriched (Fig. 3b). After the fourth round sorting, the sorted cells were cultivated on agar plate, and 15 clones were randomly picked for the characterization of individual clones. For the sequence analysis, the entire promoter and sfGFP regions were sequenced, and no mutations in the sfGFP gene were found. From the sequence analysis, we found that eight clones (4-1, 4-3, 4-4, 4-6, 4-9, 4-12, 4-13, and 4-15) and two clones (4-8 and 4-10) were the same clones, so a total of seven clones (4-1, 4-2, 4-5, 4-7, 4-8, 4-11, and 4-14) were used for the characterization (All sequence information is presented in Supplementary material, Fig. S1). During cultivation, all the clones showed similar growth profiles by entering the transition phase around 9 h (data not shown). The fluorescence intensities were analyzed in two growth phases: (i) the exponential growth phase (at 8 h after inoculation) and (ii) the stationary growth phase (at 18 h). Although SigB-dependent P cg3141 promoter has the highest activity at the transition phase (Larisch et al. 2007), we analyzed the fluorescent intensity at the stationary growth phase because sfGFP, which was used as a reporter, requires some time for maturation. The induction ratio was also calculated by dividing the fluorescence intensity value at the stationary growth phase by the value at the exponential growth phase. As shown in Fig. 4a, all clones exhibited significantly enhanced levels of sfGFP at both growth stages compared to that under the original P cg3141 . However, the SigB-dependent inducibility of the isolated promoters was very similar (around 2) or a little lower compared to that of original P cg3141 , mainly due to high expression levels in the exponential growth phase (Fig. 4a). Although we succeeded in isolating stronger promoters, those promoters also mediated high-level gene expression in the exponential growth stage as well as the stationary growth stage, which is not suitable for the growth-dependent stationary-phase gene expression system.
Design of the random promoter library and FACS screening. a stationary-phase promoter library design. The 300-bp promoter region of cg3141 was modified by randomizing the flanking regions. b Histogram in FACS screening of the random promoter library. C. glutamicum containing the empty vector pCES208 was used as negative control (gray curve), and original P cg3141 was represented by cyan curve. The histograms of original library, first round sorted cells, second round sorted cells, third round sorted cells, and fourth round sorted cells are represented by red, orange, green, blue, and magenta curves, respectively
Promoter strengths and inducibility analyses of the isolated promoters. a Fourth round sorted cells. b Negative sorted cells in the fifth round screening. White and black bars indicate the fluorescence intensities of cells at exponential growth phase (8 h) and stationary growth phase (18 h), respectively. Red bars indicate the induction ratio (fluorescent intensity at stationary growth phase/fluorescent intensity at exponential growth phase). The experiments were performed in triplicates and standard deviation is indicated
To isolate a promoter which had a greatly reduced activity in the exponential growth phase but maintained high activity in the stationary growth phase, we decided to do one more FACS screening with the fourth round sorted cells, but in this trial, FACS screening was conducted at 8 h, which is the time when the cells were still in the exponential growth phase. The cells showing lower fluorescence intensities (the bottom 1 % cells) at this time point were selectively sorted (negative sorting), assuming those cells might have the promoters with lower activity in the exponential growth phase. The cells from negative sorting were cultivated on RG agar plates for individual analyses. A total of 15 clones were randomly picked, and, among them, three clones (4-N2, 4-N3, 4-N13) were identified as the same clones by sequencing. Finally, a total 13 individual clones were characterized. (All sequence information is presented in Supplementary material, Fig. S1). The fluorescence intensities of the 13 clones were measured at the exponential growth phase (8 h) and the stationary growth phase (18 h), and the induction ratio was also calculated. The cells after the negative sorting showed relatively lower activity in the stationary growth phase (black bars) compared with the cells sorted by positive screening (Fig. 4). However, most clones in the negative sorting had a much lower expression level at the exponential growth phase (white bars), thus having relatively higher induction ratios (around 2.5 to 3.5) (Fig. 4b). Among the 13 clones isolated by negative sorting, three clones (4-N5, 4-N6, and 4-N14), which showed a relatively higher induction ratio than the others, were chosen for further analysis.
Investigation of sigB-dependent properties of the isolated promoters
From the three selected clones, plasmids were purified and transformed into wild-type and sigB-deficient C. glutamicum. Then, the sigB-dependency of the isolated promoters was further investigated. In wild-type C. glutamicum, the fluorescence intensities stayed constant or decreased during the exponential phase (Fig. 5a). The cells reached the transition phase at 9 h, and all strains showed a sudden increase of sfGFP expression immediately after the transition phase (Fig. 5a). In contrast, in the sigB-deficient strain, all isolated promoters except for P4-N6 exhibited a low and constant level of fluorescence intensities over the culture period (Fig. 5b), which indicates that the isolated promoters were highly dependent on the SigB. The promoter P4-N6 exhibited relatively higher activity than two other promoters in wild-type C. glutamicum, but it also exhibited higher activity in the sigB-deficient strain, which indicates that P4-N6 is less controllable by SigB. Finally, P4-N14 which exhibited strong promoter activity (∼20-fold higher than original promoter) and higher induction ratio (∼3.5-fold) than the other isolated promoters was selected as a strong stationary-phase promoter.
Time profiles of cell density and fluorescent intensities in wild-type C. glutamicum (a) and ΔsigB mutant (b). Symbols: circle (○), pCES208; triangle (△), pCES-P4-N5-sfGFP; square (□), pCES-P4-N6-sfGFP; diamond (◇), pCES-P4-N14-sfGFP. Closed and open symbols indicate the cell density (OD 600 nm) and fluorescent intensities, respectively. The experiments were performed in duplicate and standard deviation is indicated
Next, the promoter P4-N14 was compared with a strong constitutive synthetic promoter PH36 (Yim et al. 2013) in two different culture media: defined medium and semi-defined medium. In both media, the expression of sfgfp gene under P4-N14 showed auto-inducible profiles, by showing a constant sfGFP expression before the transition phase and rapidly increasing expression after the transition phase, showing 3 ∼ 3.5-fold higher sfGFP expression level (Supplementary material, Fig. S2). In contrast, the sfGFP expression under PH36 was constantly increasing throughout the exponential and stationary growth phases.
Production of GST in fed-batch cultivation
To demonstrate the usability of the isolated promoter (P4-N14) in large-scale cultivation, a fed-batch cultivation of C. glutamicum harboring pCES-P4-N14-GST, in which GST expression was controlled under P4-N14, was conducted in 5-L lab-scale bioreactor. Cell-specific growth rate (μ) was significantly decreased (0.26 h−1 → 0.02 h−1) after the cells reached the stationary phase (15 h) (Fig. 6a). During the cultivation, cells were periodically collected and the production of GST was analyzed by SDS-PAGE analysis and Western blot. At the initial time point (0 h), the GST band was detected in the SDS-PAGE and Western blot (lane 1 in Fig. 6b, c), which might have been accumulated during the seed culture. But over the entire exponential growth phase, GST bands were not detected, which means the GST was not produced in this period (lanes 2–7 in Fig. 6b, c). At 13 h after inoculation, cells began to enter the stationary growth phase, and the protein bands began to appear at 17 h, when cells were in the stationary growth phase (lane 8 in Fig. 6b, c). The expression level of GST stayed high throughout the stationary growth phase (lanes 9–12 in Fig. 6b, c).
Fed-batch cultivation of C. glutamicum harboring pCES-P4-N14-GST. a Time profile of cell growth. Symbols: ● cell density (OD 600 nm). b SDS-PAGE analysis of proteins in whole cell lysates. c Western blot analysis of total protein fractions. Lane M, molecular weight markers (kDa). Lanes 1–12, samples at times 0, 3, 6, 9, 11, 13, 15, 17, 21, 25.5, 29, and 33.5 h, respectively. The arrowheads indicate the GST protein bands. The experiments were performed in triplicates and standard deviation of the optical density is indicated
Discussion
For the microbial production of recombinant proteins, one of the most important strategies is controlling gene expression by promoters, and various types of promoters have been developed to increase production yield (Liu et al. 2015). Among such promoters, auto-inducible promoters have many advantages for the industrial-scale microbial production of recombinant proteins because they can allow fast initial growth of the cells and the initiation of protein production at a desired point without adding inducers (Nocadello and Swennen 2012). In several bacterial strains, different types of auto-inducible gene expression systems have been studied that are triggered by certain environmental changes, including nutrient, oxygen, and pH (Chou et al. 1995; Khosla and Bailey 1989; Miksch et al. 2005). In this work, by engineering the SigB-dependent cg3141 promoter, we successfully developed a stationary-phase gene expression system that is suitable for recombinant protein production in C. glutamicum. First, we investigated the activities of the previously known SigB-dependent promoters on recombinant protein production and determined that P cg3141 showed the most SigB-dependent behavior. Then, we constructed a synthetic promoter library based on P cg3141 , and the engineered inducible promoters could be successfully isolated by a total of five rounds of FACS screening. The isolated promoters showed up to a 40-fold increased sfGFP expression level compared to the original cg3141 promoter with high inducibility. Regarding the poor activity of P cg0096 , we may consider the wrong prediction of promoter for cg0096 gene. The promoter for cg0096 gene was previously predicted based on RACE-PCR analysis (Larisch et al. 2007); however, the activity of P cg0096 has never been examined in any other reports yet before our work. Recently, Brune et al. (2012) suggested the possible relation of Cg0096 (hypothetical protein) and biotin biosynthesis. The cg0096 gene is located in the downstream of bioB gene (one of the biotin biosynthesis genes), and they suggested that cg0096 gene is organized as an operon with bioB and its expression might be regulated together with the biotin biosynthesis gene under the promoter located upstream of bioB gene. If this hypothesis is correct, the 500-bp region which we used for the expression of cg0096 gene does not function as a promoter.
For isolation of the engineered stationary-phase promoters, we used a FACS screening strategy that combined positive and negative screening methods. Cells containing promoters with strong activities were sorted in the first four consecutive rounds of screening, and to isolate the promoters with high inducibility, negative FACS sorting was performed in the final round by sorting the clones showing the lowest sfGFP signal at the exponential growth phase. In the positive screening, the cells containing stronger promoters could be isolated, but it was not certain whether the higher fluorescent intensities in the sorted cells resulted from the induction of gene expression in just the stationary growth phase. As shown in Fig. 4a, most clones exhibited a relatively low induction ratio, although much higher gene expression levels (up to 65-fold compared to original promoter) were achieved. Those false-positive clones having strong activity but low inducibility could be eliminated by one negative sorting in the final round. After that negative sorting, the isolated clones showed a relatively lower sfGFP signal than those in clones sorted by the former positive screening, but a much higher inducibility (up to 3.5 fold) could be achieved (Fig. 4b). This induction ratio (3.5-fold) is quite competitive compared to those of other auto-inducible promoter systems used in other bacteria: about 3 ∼ 4-fold increase of GFP and β-galactosidase after the transition phase in E. coli using the strong synthetic stationary-phase promoter (Miksch et al. 2005) and 6-fold increase of xylanase activity in B. subtilis using SigB-dependent ohrB promoter (Panahi et al. 2014).
Compared to the original cg3141 promoter, the promoters isolated by FACS screening exhibited 5- to 40-fold elevated promoter strengths, but no consensus sequence was found in the isolated promoters (Supplementary material, Fig. S1). From these sequence information, it was not easy to find the exact sequence changes that were critical for promoter activity, but this result indicates that the sequences of randomized regions including flanking and spacer regions also have a crucial role in modulating the promoter strength and inducibility as previously described (Jensen and Hammer 1998; Hammer et al. 2006). Also, we found that there was relatively high-level background of target proteins in the lag or early exponential phase, which was also observed in other auto-inducible promoters previously developed in other bacterial strains (Miksch et al. 2005; Panahi et al. 2014). Most auto-inducible promoters have a characteristic of constitutive expression after turning the activity on and, because they lack a shutdown regulation system, the proteins continue to be produced. When the solution from pre-cultivation was transferred to a new fresh media, the proteins which were actually produced in the pre-cultivation remained in the new culture at the lag or early exponential growth phase. For tighter control of the cg3141-derived promoter, we can consider introducing an additional regulation system, which would inhibit the activation of the promoter under aerobic and exponential growth conditions. The cg3141 gene encodes flavohemoprotein to detoxify the stress from nitrogen oxide at high cell densities (Platzen et al. 2014), and it is known that the activity of P cg3141 can be regulated by a transcriptional repressor ArnR in addition to SigB (Nishimura et al. 2014; Nishimura et al. 2008). Under aerobic conditions (mainly the exponential growth phase), ArnR represses the expression under P cg3141 , and the repression is relieved during nitrate respiration (transition and early stationary growth phase). Introducing this additional ArnR-based regulation system together with SigB can be a good strategy to effectively regulate the stationary-phase gene expression system. Although the stationary growth phase may not be a preferable environment for cell growth and protein production because of substrate exhaustion, accumulation of waste metabolites etc., there are also many products which production prefers the stationary phase than exponential phase. For example, glutamate decarboxylase (GAD) necessary for the biosynthesis of γ–aminobutyric acid (GABA), has the optimal pH around 4.5 which is much lower than the optimal pH for growth of C. glutamicum (Okai et al. 2014). So, direct conversion for GABA is often initiated in the stationary growth phase when the culture pH is lower (Takahashi et al. 2012). The GAD enzyme is not necessary in the exponential growth phase, so the production of this enzyme at stationary phase may be useful.
In conclusion, we developed a strong stationary-phase promoter useful for gene expression in C. glutamicum from the SigB-dependent cg3141 promoter. The isolated promoter exhibited high inducibility (∼3.5-fold) which turned on at the transition phase, and it also exhibited stronger (20-fold) activity compared to the original cg3141 promoter. To the best of our knowledge, this is the first report on the development of a synthetic stationary-phase promoter in C. glutamicum. We believe this stationary-phase promoter will contribute to extend the usefulness of C. glutamicum in the industrial-scale production of various recombinant proteins as well as value-added biochemicals.
References
Becker J, Wittmann C (2012) Bio-based production of chemicals, materials and fuels–Corynebacterium glutamicum as versatile cell factory. Curr Opin Biotechnol 23:631–640
Brune I, Götker S, Schneider J, Rodionov DA, Tauch A (2012) Negative transcriptional control of biotin metabolism genes by the TetR-type regulator BioQ in biotin-auxotrophic Corynebacterium glutamicum ATCC 13032. J Biotechnol 159:225–234
Cao Y, Xian M (2011) Production of phloroglucinol by Escherichia coli using a stationary-phase promoter. Biotechnol Lett 33:1853–1858
Choi JW, Yim SS, Lee SH, Kang TJ, Park SJ, Jeong KJ (2015) Enhanced production of gamma-aminobutyrate (GABA) in recombinant Corynebacterium gluatamicum by expressing glutamate decarboxylase active in expanded pH range. Microb Cell Factories 1:1–11
Chou CH, Aristidou AA, Meng SY, Bennett GN, San KY (1995) Characterization of a pH-inducible promoter system for high-level expression of recombinant proteins in Escherichia coli. Biotechnol Bioeng 47:186–192
Donovan RS, Robinson C, Glick B (1996) Review: optimizing inducer and culture conditions for expression of foreign proteins under the control of the lac promoter. J Ind Microbiol 16:145–154
Ehira S, Shirai T, Teramoto H, Inui M, Yukawa H (2008) Group 2 sigma factor SigB of Corynebacterium glutamicum positively regulates glucose metabolism under conditions of oxygen deprivation. Appl Environ Microbiol 74:5146–5152
Halgasova N, Bukovska G, Ugorcakova J, Timko J, Kormanec J (2002) The Brevibacterium flavum sigma factor SigB has a role in the environmental stress response. FEMS Microbiol Lett 216:77–84
Hammer K, Mijakovic I, Jensen PR (2006) Synthetic promoter libraries–tuning of gene expression. Trends Biotechnol 24:53–55
Hansen LH, Knudsen S, Sørensen SJ (1998) The effect of the lacY gene on the induction of IPTG inducible promoters, studied in Escherichia coli and Pseudomonas fluorescens. Curr Microbiol 36:341–347
Huang D, Holtz WJ, Maharbiz MM (2012) A genetic bistable switch utilizing nonlinear protein degradation. J Biol Eng 6:9
Ikeda M, Nakagawa S (2003) The Corynebacterium glutamicum genome: features and impacts on biotechnological processes. Appl Microbiol Biotechnol 62:99–109
Jensen PR, Hammer K (1998) The sequence of spacers between the consensus sequences modulates the strength of prokaryotic promoters. Appl Environ Microbiol 64:82–87
Kalinowski J, Bathe B, Bartels D, Bischoff N, Bott M, Burkovski A, Dusch N, Eggeling L, Eikmanns BJ, Gaigalat L, Goesmann A, Hartmann M, Huthmacher K, Krämer R, Linke B, McHardy AC, Meyer F, Möckel B, Pfefferle W, Pühler A, Rey DA, Rückert C, Rupp O, Sahm H, Wendisch VF, Woegräbe I, Tauch A (2003) The complete Corynebacterium glutamicum ATCC 13032 genome sequence and its impact on the production of L-aspartate-derived amino acids and vitamins. J Biotechnol 104:5–25
Khosla C, Bailey JE (1989) Characterization of the oxygen-dependent promoter of the vitreoscilla hemoglobin gene in Escherichia coli. J Bacteriol 171:5595–6004
Kinoshita S, Udaka S, Shimono M (1957) Studies on the amino acid fermentation. J Gen Appl Microbiol 3:193–205
Larisch C, Nakunst D, Hüser AT, Tauch A, Kalinowski J (2007) The alternative sigma factor SigB of Corynebacterium glutamicum modulates global gene expression during transition from exponential growth to stationary phase. BMC Genomics 8:4
Lipscomb ML, Mark CM, Dhinakar SK (2004) Production of a secreted glycoprotein from an inducible promoter system in a perfusion bioreactor. Biotechnol Prog 20:1402–1407
Liu X, Yang Y, Zhang W, Sun Y, Peng F, Jeffrey L, Harvey L, McNeil B, Bai Z (2015) Expression of recombinant protein using Corynebacterium glutamicum: progress, challenges and applications. Criti Rev Biotechnol 15:1–13
Mijakovic I, Petranovic D, Jensen PR (2005) Tunable promoters in systems biology. Curr Opin Biotechnol 16:329–335
Miksch G, Bettenworth F, Friehs K, Flaschel E, Saalbach A, Twellmann T, Nattkemper TW (2005) Libraries of synthetic stationary-phase and stress promoters as a tool for fine-tuning of expression of recombinant proteins in Escherichia coli. J Biotechnol 120:25–37
Nishimura T, Teramoto H, Inui M, Yukawa H (2014) Corynebacterium glutamicum ArnR controls expression of nitrate reductase operon narKGHJI and nitric oxide (NO)-detoxifying enzyme gene hmp in an NO-responsive manner. J Bacteriol 196:60–69
Nishimura T, Teramoto H, Vertès AA, Inui M, Yukawa H (2008) ArnR, a novel transcriptional regulator, represses expression of the narKGHJI operon in Corynebacterium glutamicum. J Bacteriol 190:3264–3273
Nocadello S, Swennen EF (2012) The new pLAI (lux regulon based auto-inducible) expression system for recombinant protein production in Escherichia coli. Microb Cell Factories 11:1–10
Okai N, Takahashi C, Hatada K, Ogino C, Kondo A (2014) Disruption of pknG enhances production of gamma-aminobutyric acid by Corynebacterium glutamicum expressing glutamate decarboxylase. AMB Express 4:20
Oguiza JA, Marcos AT, Martin JF (1997) Transcriptional analysis of the sigA and sigB genes of Brevibacterium lactofermentum. FEMS Microbiol Lett 153:111–117
Panahi R, Vasheghani-Farahani E, Shojaosadati S, Bambai B (2014) Auto-inducible expression system based on the SigB-dependent ohrB promoter in Bacillus subtilis. Mol Biol 48:852–857
Park JH, Kwon HW, Jeong KJ (2013) Development of a plasmid display system with an Oct-1 DNA-binding domain suitable for in vitro screening of engineered proteins. J Biosci Bioeng 116:246–252
Park JU, Jo JH, Kim YJ, Chung SS, Lee JH, Lee HH (2008) Construction of heat-inducible expression vector of Corynebacterium glutamicum and C. ammoniagenes: fusion of lambda operator with promoters isolated from C. ammoniagenes. J Microbiol Biotechnol 18:639–647
Park KJ, Lee CH, Kim A, Jeong KJ, Kim CH, Kim YS (2012) Death receptors 4 and 5 activate Nox1 NADPH oxidase through riboflavin kinase to induce reactive oxygen species-mediated apoptotic cell death. J Biol Chem 287:3313–3325
Park SH, Kim HU, Kim TY, Park JS, Kim SS, Lee SY (2014) Metabolic engineering of Corynebacterium glutamicum for L-arginine production. Nat Commun 5:4618
Pátek M, Nešvera J (2011) Sigma factors and promoters in Corynebacterium glutamicum. J Biotechnol 154:101–113
Pédelacq JD, Cabantous S, Tran T, Terwilliger TC, Waldo GS (2006) Engineering and characterization of a superfolder green fluorescent protein. Nat Biotechnol 24:79–88
Platzen L, Koch-Koerfges A, Weil B, Brocker M, Bott M (2014) Role of flavohaemoprotein Hmp and nitrate reductase NarGHJI of Corynebacterium glutamicum for coping with nitrite and nitrosative stress. FEMS Microbiol Lett 350:239–248
Sambrook J, Russell DW (2001) Molecular cloning. A laboratory manual, Third edn. Cold Spring Harbor Laboratory, New York
Schafer A, Tauch A, Jager W, Kalinowski J, Thierbach G, Puhler A (1994) Small mobilizable multi-purpose cloning vectors derived from the Escherichia coli plasmids pK18 and pK19: selection of defined deletions in the chromosome of Corynebacterium glutamicum. Gene 145:69–73
Takahashi C, Shirakawa J, Tsuchidate T, Okai N, Hatada K, Nakayama H, Tateno T, Ogino C, Kondo A (2012) Robust production of gamma-amino butyric acid using recombinant Corynebacterium glutamicum expressing glutamate decarboxylase from Escherichia coli. Enzym Microb Technol 51:171–176
Wanner BL, Wilmes MR, Young DC (1988) Control of bacterial alkaline phosphatase synthesis and variation in an Escherichia coli K-12 phoR mutant by adenyl cyclase, the cyclic AMP receptor protein, and the phoM operon. J Bacteriol 170:1092–1102
Woo HM, Park JB (2014) Recent progress in development of synthetic biology platforms and metabolic engineering of Corynebacterium glutamicum. J Biotechnol 180:43–51
Yim SS, An SJ, Kang M, Lee J, Jeong KJ (2013) Isolation of fully synthetic promoters for high-level gene expression in Corynebacterium glutamicum. Biotechnol Bioeng 110:2959–2969
Acknowledgments
This work was supported by the Intelligent Synthetic Biology Center of Global Frontier Project (Grant no. NRF-2014M3A6A8066443) and by the National Research Foundation of Korea (Grant no. NRF-2015R1A2A2A01007674) funded by the Ministry of Science, ICT and Future Planning (MSIP).
Author information
Authors and Affiliations
Corresponding author
Ethics declarations
This article does not contain any studies with human participants or animals performed by any of the authors.
Competing interests
All the authors declare that they have no competing interests.
Electronic supplementary material
ESM 1
(PDF 246 kb)
Rights and permissions
About this article
Cite this article
Kim, M.J., Yim, S.S., Choi, J.W. et al. Development of a potential stationary-phase specific gene expression system by engineering of SigB-dependent cg3141 promoter in Corynebacterium glutamicum . Appl Microbiol Biotechnol 100, 4473–4483 (2016). https://doi.org/10.1007/s00253-016-7297-y
Received:
Revised:
Accepted:
Published:
Issue Date:
DOI: https://doi.org/10.1007/s00253-016-7297-y